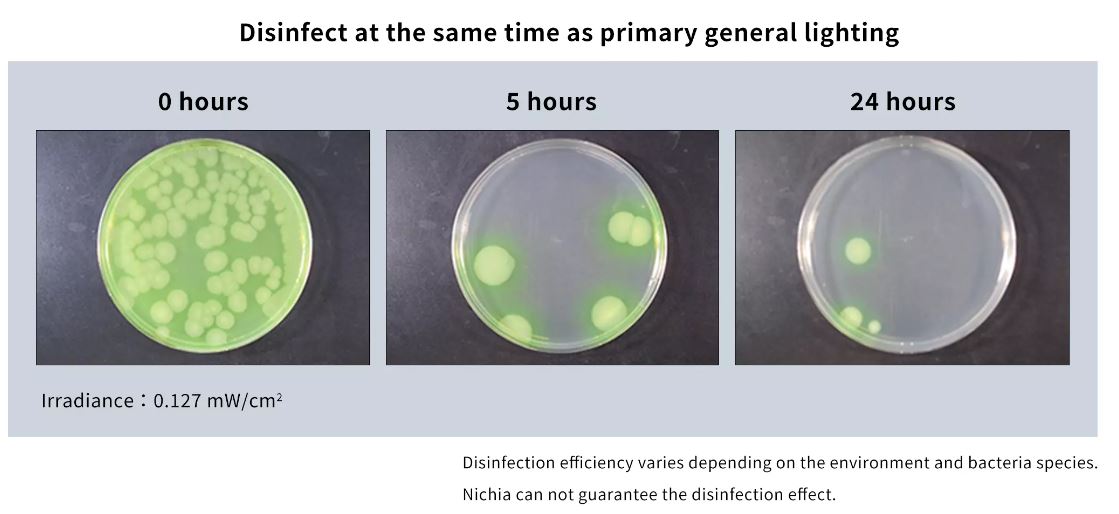

News
-

Cree LED Expands J Series® 3030S Portfolio with Pro9™ LEDs
Cree LED announces the expansion of its proven J Series® 3030 portfolio with the introduction of four new high-performance LEDs. Designed in a 757-compatible 3.0 × 3.0 mm footprint, the new J Series 3030S LEDs deliver improved price-performance, industry-leading efficacy and seamless drop-in comp...Read more -

Sanan–Lumileds Deal Collapses Amid U.S. National Security Concerns
A planned acquisition of Dutch-based LED manufacturer Lumileds by Sanan Optoelectronics has been officially terminated after intervention from U.S. regulators, underscoring the growing impact of geopolitical tensions on the global LED industry. The proposed US$...Read more -

CIE Webinar: “Lighting the Way: Finding Balance Between Safety, Beauty and the Night Sky”
The CIE invites you to join its upcoming special webinar entitled “Lighting the Way: Finding Balance Between Safety, Beauty, and the Night Sky” on the topic of light pollution, in celebration of the International Day of Light 2026 (16 May). The webinar will take place on Friday, May 1...Read more -

The next wave of LED lighting: Smarter, circular and more efficient
As the world enters the Age of Electricity, lighting remains one of the most visible – and widespread – parts of our energy use. The IEA estimates that lighting in buildings and outdoor applications accounts for the majority of overall lighting electricity demand. In 202...Read more -

Luminus LUX Pro & Gen6+ COBs Redefine LED Performance
Luminus Devices today announced two Chip-on-Board (COB) LED platforms: LUX Pro and Gen6+. Purposefully differentiated, the platforms give lighting architects, engineers, and OEMs a clear choice: premium color quality and high efficacy with LUX Pro, or proven mainstream performance and unmatche...Read more -

MEAN WELL Expands Smart Lighting Horizons with the New SPWM Series
MEAN WELL, the global leader in standard power supplies, continues to set the pace for the lighting industry with the official launch of the SPWM-75/150/240 series. This new line of constant voltage dimmable LED drivers is engineered to complement the world-renowned PWM series, offering enhanced ...Read more -

Lumileds San Jose Facility Set to Close as Layoffs Continue
Manufacturing of LEDs and related components in the United States is rare. It just got rarer. In November, we reported that LED manufacturer Lumileds planned to eliminate 61 roles at its San Jose operations while transferring portions of its manufacturing work to Asia. At the time, the company c...Read more -
Technical points of LED industrial and mining lights
Due to the high heat generation of LED high bay lights, the quality of Led high bay lights is very limited, because high temperature accelerates chip aging, light decay, color shift, and shortens the life of LED high bay lights. To solve this problem, it is necessary to re-radiate heat and increa...Read more -

Ennostar and PlayNitride Join Forces to Develop Micro LED, and Value of Market for Display-Related Micro LED Chips Will Reach Around US$542 Million in 2024, Says TrendForce
Nov. 11, 2022 —- Ennostar’s subsidiary Epistar and PlayNitride’s wholly-owned subsidiary PlayNitride Display have announced that they have teamed up to build a production line for 6-inch Micro LED epi-wafers. Looking at the latest progress in the development of Micro LED, large-sized displa...Read more -

Nichia expands the portfolio of its Direct Mountable Chip Series, a high luminous flux density chip scale LED
Tokushima, Japan – 17 November 2022: Nichia, the world’s largest LED manufacturer and inventor of high-brightness blue and white LEDs, is pleased to announce the addition of the new NCSWE13A-V1 to its high luminous flux density Direct Mountable Chip portfolio. The new NCSWE13A-V1 is a 1W-class ...Read more -
A dual function LED for general illumination and disinfection
NF2W585AR-P8 is a dual function LED that provides both white light and high doses of energy geared for inactivation of various prevalent bacteria. With a 405nm wavelength1 die known to be effective in sterilization, this LED can be used to inactivate bacteria, such as bacteria known to cause food...Read more -

Wavelength stable green InGaN micro LEDs monolithically grown on silicon substrate
IMAGE: (A) SCHEMATIC OF THE INGAN/AGAN MULTIPLE-QUANTUM-WELL NANOWIRE ARRAY. (B) THE PEAK WAVELENGTH OF THE DEVICE’S ELECTROLUMINESCENCE STAYS CONSTANT OVER ONE ORDER OF MAGNITUDE OF CHANGE IN CURRENT INJECTION. (C) THE CURRENT VOLTAGE CHARACTERISTICS OF A DEVICE THAT SHOWS GOOD RECTIFICATION RA...Read more











